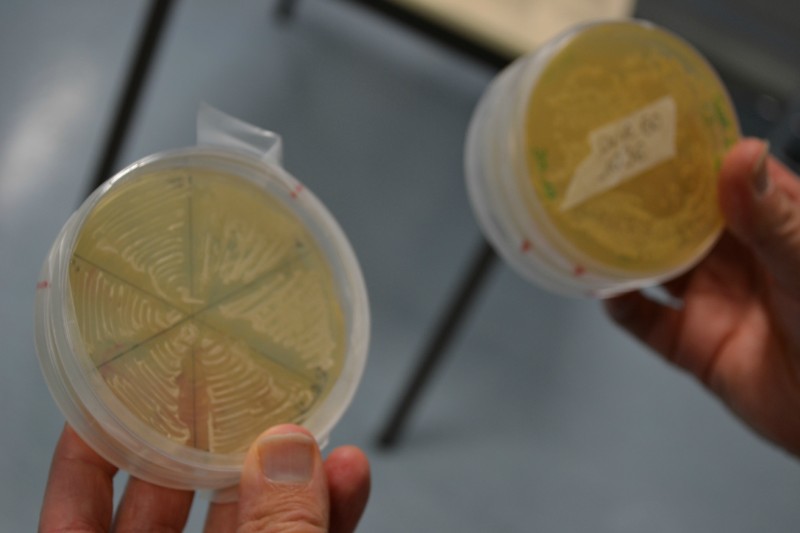
Boîte de pétri

L’évolution des techniques d’analyse microbiologique brise certaines certitudes œnologiques et apporte de nouvelles connaissances sur l’écologie des levures à la parcelle, au chai et dans le vin. Levures saccharomyces et non-saccharomyces contribuent-elles à l’expression du terroir ?
Le cycle de conférences Vigne, vin et vignerons de l’Université de Haute Alsace proposait à la microbiologiste Michèle Guilloux-Bénatier, vice-directrice de l’Institut universitaire de la vigne et du vin (IUVV) à Dijon, d’exposer les travaux de recherche effectués dans son laboratoire de l’IUVV dans une conférence intitulée « Levures de terroir indigènes ou exogènes, quelle réalité ? »
Les travaux portent sur l’écologie des levures à la parcelle, au chai et dans les vins. Avec cette question globale qui taraude les vignerons : y a-t-il une écologie des levures propre au terroir ? Et les levures d’une parcelle et/ou du chai influencent-elles le profil organoleptique des vins ?
Quelques saccharomyces à la parcelle
Depuis 10-15 ans, l’avènement des techniques analytiques d’identification génétique, dites PCR, a commencé à apporter quelques éléments de réponse. Le laboratoire s’est penché sur l’identification des levures dans les parcelles, au sol, sur grappes, sur feuilles, sur les sarments et le tronc, pour finalement constater qu’il y a une grande biodiversité de microflore épiphytique levurienne à la parcelle. Une étude a par exemple identifié jusqu’à 90 espèces de levures et de l’ordre de 100 000 à 10 millions de cellules par grammes à la surface des végétaux.
Une autre étude sur chardonnays de Bourgogne identifie 36 genres de levures. « En fait, 27 genres occupent moins de 0,5 % de la population. » Ne représentant que 0,03 % de la population, les levures du genre saccharomyces sont finalement très rares dans cette extraordinaire biodiversité au vignoble. « Il y a donc des saccharomyces au vignoble, mais très peu. » Ce qui contredit au passage certains articles qui affirmaient qu’il n’y en avait pas du tout… « On serait passé à côté si on n’avait pas eu de technique fine d’analyse. » La question était alors de savoir si ce sont ces quelques rares saccharomyces qui fermentent les vins…
Les levures du chai ont toutes les chances de s’imposer
Les chercheurs ont alors poursuivi leurs travaux d’identification génétique des populations levuriennes jusque dans les chais - à la surface des murs, des sols, de la vaisselle vinaire, des pompes, des cuves - et dans les vins qui fermentent. Suite à la demande de domaines voulant réaliser des levains indigènes, une étude a porté sur quatre sites de vinification en Bourgogne et a abouti aux mêmes conclusions. Parmi 578 souches identifiées, « il n’y a pas au chai d’individu dominant, il y a une grande diversité génétique », et une variabilité spatio-temporelle. Des mêmes individus sont retrouvés dans plusieurs sites.
Une étude sur des chardonnays du Mâconnais a ensuite poussé l’identification génétique jusque dans des vins en fermentation au chai du BIVB, avec plusieurs modalités de démarrage de fermentation, dont l’une consiste à prélever des raisins à la parcelle et à les introduire dans un contenant stérile, de manière à s’assurer que ce sont bien les souches de la parcelle qui fermentent le raisin. Malgré les précautions de stérilité préliminaire des outils de prélèvement, « le milieu s’est colonisé en levures qui probablement résidaient dans le chai ». Un chai pourtant très « clean »… Comme il est régulièrement décrit dans la littérature, ces études par PCR ont confirmé que les levures se propagent notamment par les gaz de fermentation, qu’il y a des échanges de cuve à cuve et qu’il y a d’autres voies de propagation entomophile ou humaine. Et qu’il est donc très difficile, voire impossible, dans un environnement levurien tel que celui d’un chai en fermentation d’imposer telle ou telle souche… D’ailleurs, sur les histogrammes de populations présentés rarement, ou plutôt jamais, une fermentation ne s’effectue avec une seule souche.
Très récemment, les chercheurs ont accès à une nouvelle technique d’identification des populations levuriennes, en service à Geisenheim, beaucoup plus puissante, car plus rapide et moins coûteuse que l’analyse génétique par PCR. Les boîtes de Petri, qui contiennent les isolats sur milieu de culture levurien, sont directement passées par analyseur infrarouge dit IRFT. L’analyse du spectre IR rend compte du type de levure. Ce qui fait que les chercheurs analysent à présent des milliers de prélèvements, leur conférant un regard sur les populations levuriennes statistiquement plus significatif.
« Globalement, les levures du raisin sont peu implantées dans le vin. Pas mal de chercheurs ont trouvé les mêmes conclusions. Et donc si l’on veut travailler son écologie des levures, cela se travaille surtout à la cuverie », estime Michèle Guilloux-Bénatier.
La diversité laminée par le cuivre et le sulfitage
Avec ces nouvelles techniques d’analyses par IRFT, les travaux se poursuivent actuellement sur les levures non-saccharomyces (LNSc). Des levures qui fermentent également les sucres du raisin, mais qui globalement dans une fermentation cèdent la place ensuite aux saccharomyces plus résistantes à l’alcool. Intervenant en début de fermentation, les LNSc peuvent donc jouer un rôle dans le profil des vins. Les histogrammes de populations levuriennes au cours de différents profils fermentaires montrent que, sous certaines conditions de sulfitage ou en présence de cuivre résiduel, les saccharomyces s’implantent très tôt et durablement dans la fermentation. Par contre, sans sulfitage et sans cuivre résiduel, il y a toute une cohorte de levures non-saccharomyces qui fermentent - cela peut aller jusque 6 % d’alcool acquis - avant d’être supplantées par des saccharomyces, plus résistantes à l’alcool. Le sulfitage à la vendange et le cuivre résiduel sont donc deux facteurs sélectifs, c’est-à-dire qui limitent la colonisation du jus par des LNSc et favorisent très rapidement les saccharomyces, indique dans la discussion Michèle Guilloux-Bénatier. Cuivre et sulfitage laminent la biodiversité levurienne.
Le cas des non-saccharomyces
Alors faut-il favoriser les débuts de fermentations par les LNSc ? La littérature œnologique, ainsi que « des témoignages de praticiens, notamment en Afrique du Sud, trouvent les vins plus intéressants avec des levures de fermentation non-saccharomyces. Donc on s’y est intéressé. » Leur pratique consiste à n’implanter des levains de saccharomyces qu’après quelques pourcents d’alcool acquis, ceci de manière à profiter du profil aromatique acquis par un début de fermentation par des LNSc, soit un levurage exogène après deux à trois jours de fermentation alcoolique.
Si le transfert parcelle - vin des levures saccharomyces a finalement très peu de chance statistiquement de se produire, c’est plutôt du côté des LNSc que les regards des chercheurs de Dijon pourraient apporter un nouvel éclairage à l’œnologie : « Certaines souches de LNSc à la parcelle se retrouvent dans le vin. Sur une étude, on a retrouvé 7 souches sur 21 identifiées à la parcelle », un transfert important certaines années, et d’autres pas. L’exemple d’Hanseniaspora uvarum est donné avec des transferts vigne - chai - vin de souches retrouvées certaines années, d’autres pas ou peu. « On a aussi vu que certaines souches de LNSc résistent dans la cuverie et recolonisent les jus l’année suivante. »
Pour l’heure, les chercheurs ne souhaitent certainement pas s’aventurer sur l’hypothèse qu’un lien microbiologique parcelle - vin pourrait reposer notamment sur ces levures non-saccharomyces, sous certaines conditions d’itinéraire sans sulfitage sur vendange et sur moût et sans cuivre résiduel. Hypothèse hasardeuse d’autant qu’en matière de microbiologie, c’est l’évolution de la finesse des techniques d’analyse qui permet de réviser les certitudes d’hier. Par exemple, il y a 5 - 6 ans, une nouvelle forme d’état de survie des levures, l’état viable non cultivable, a fait prendre conscience aux microbiologistes que des micro-organismes pouvaient passer à travers les techniques et méthodes de détection. Ce qui explique par exemple que des vins embouteillés peuvent être considérés comme dénués de tout germe, après leur mise en culture microbiologique, alors qu’en réalité des germes sont présents, mais ne sont pas cultivables sur milieu de culture en boîte de Petri.
Quelle que soit leur signature chimique dans les vins, les non-saccharomyces de la parcelle ou du chai ont une contribution au profil aromatique et gustatif final des vins qui reste à évaluer. Mais il est clair que la connaissance progresse considérablement actuellement et ouvre de nouvelles perspectives. Les chercheurs de l’IUVV vont notamment s’intéresser au comportement de la flore levurienne selon différents itinéraires d’élevage, dans différents types de chais soumis à plus ou moins de sanitation. Une actualisation des connaissances œnologiques s’impose dès que les thèses seront mises en ligne.